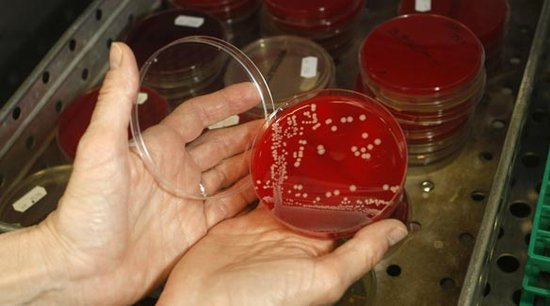
研究人员在野生动物中发现耐药性超级细菌

腾讯科学讯(过客/编译)根据《野生动物疾病》杂志的一项最新研究,人类当中最臭名昭著和最难以治疗的细菌之一发现于野生动物当中。研究人员从两只兔子和一只沙鸥中分离出了耐甲氧西林金黄色葡萄球菌(MRSA)。
转播到腾讯微博
野生动物当中出现最臭名昭著的耐甲氧西林金黄色葡萄球菌
转播到腾讯微博

兔子身上的耐甲氧西林金黄色葡萄球菌(MRSA)也对四环素有抗性,史密斯称这在农场动物中是普遍存在的
金黄色葡萄球菌会导致皮肤感染,如果进入血液就会导致威胁生命的疾病。大多数传染病都很容易用盘尼西林和相关的抗生素进行处理,但是耐甲氧西林金黄色葡萄球菌(MRSA)会呈现上升的趋势,它也被称作“超级细菌”,每年大约会杀死18000名美国人。在大部分情况下,人们由于住院感染了这种细菌。医院是耐药细菌的滋生地,因为人们的治疗会使用各种各样的抗菌药物,这就促使病原体进化出抗药性。
这种情况十多年前就已经清楚了,然而人们也能够在医院之外获得耐甲氧西林金黄色葡萄球菌(MRSA)。比如说,畜牧场的猪就被发现含有这种细菌,很可能是因为在它们生长的过程中农民在食物中添加了抗生素,这是进化出抗药性的另一种方式。其它的研究已经在宠物和动物园动物身上发现了耐甲氧西林金黄色葡萄球菌(MRSA),它们或许是被人类管理员所传染。
现在似乎野外的动物们能够被耐甲氧西林金黄色葡萄球菌(MRSA)所感染。爱荷华大学的流行病学家塔拉-史密斯带领的研究人员们在进入野生动物护理中心的114只动物身上收集到了样本。其中的7只动物或者说6.1%携带着对于甲氧西林敏感的金黄色葡萄球菌。这些动物包括猫头鹰、鸽子、一只海狸、一只苍鹭和一只松鼠。有三只动物携带着耐甲氧西林金黄色葡萄球菌(MRSA)。
一个大问题是这些物种是如何携带上耐甲氧西林金黄色葡萄球菌(MRSA)。一名兽医兼动物学家的乔治-费雷拉在瑞士担任会诊医生时说道:“这真的非常难以了解来源,特别是候鸟这些动物。”他一直都在研究人类和它们的宠物身上存在的耐甲氧西林金黄色葡萄球菌(MRSA)。我们假定这些受感染的动物从未接受过抗生素,那么它们一定是从它们所处的环境直接获得的细菌。
分离出来的细菌类型表明这只沙鸥携带着一种与医院有关的耐甲氧西林金黄色葡萄球菌(MRSA)。兔子身上的耐甲氧西林金黄色葡萄球菌(MRSA)也对四环素有抗性,史密斯称这在农场动物中是普遍存在的。
或许最伤脑筋的是携带着仍然对甲氧西林敏感的葡萄球菌的一只鸽子,它对抗菌万古霉素产生抗药性。史密斯实验室的助理研究员同时也是研究的合著者Shylo Wardyn说道:“在耐甲氧西林金黄色葡萄球菌(MRSA)的传染病治疗中万古霉素是作为一种最后的手段。而且在人类当中对万古霉素有抵抗力的葡萄球菌是很罕见的。”
史密斯说道,是否环境当中的野生动物是耐甲氧西林金黄色葡萄球菌(MRSA)一个储存器,是否它们能够把超级细菌传播给动物和人类仍然是一个未解决的问题。这些感染能够从人类中传播出来,比如说医院垃圾、污水或者农业。而且我们不清楚的是是否动物们能够摆脱自身的感染、它们是否能够交叉感染或者它们是否曾经把病毒传播回人类。
费雷拉的研究表明狗和它们的主人能够将反复的传播耐甲氧西林金黄色葡萄球菌(MRSA),而且野生动物也是人类感染的另一个众所周知的途径,比如说鹿和莱姆病、老鼠和汉坦病毒。虽然提出这样的证据,但是需要进行更多的研究来了解人类是否能够从野生动物感染耐甲氧西林金黄色葡萄球菌(MRSA)。